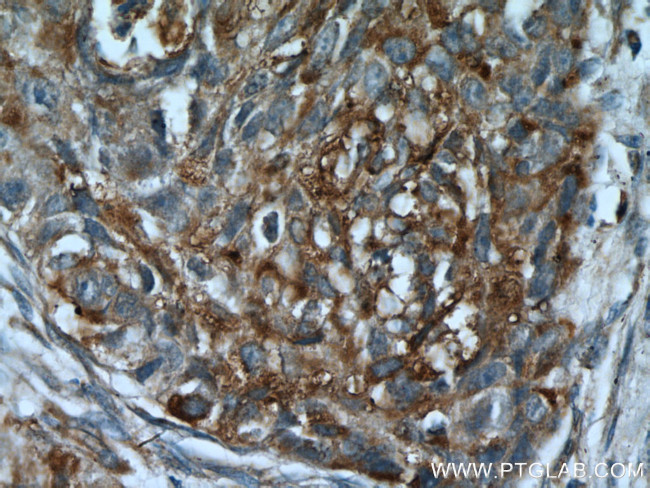
PLUNC Antibody in Immunohistochemistry (Paraffin) (IHC (P))

Search
Proteintech
PLUNC Polyclonal Antibody
{{$productOrderCtrl.translations['antibody.pdp.commerceCard.promotion.promotions']}}
{{$productOrderCtrl.translations['antibody.pdp.commerceCard.promotion.viewpromo']}}
{{$productOrderCtrl.translations['antibody.pdp.commerceCard.promotion.promocode']}}: {{promo.promoCode}} {{promo.promoTitle}} {{promo.promoDescription}}. {{$productOrderCtrl.translations['antibody.pdp.commerceCard.promotion.learnmore']}}
产品信息
10413-1-AP
种属反应
宿主/亚型
分类
类型
抗原
偶联物
形式
浓度
规格
纯化类型
保存液
内含物
保存条件
运输条件
产品详细信息
Immunogen sequence: MFQTGGLIV FYGLLAQTMA QFGGLPVPLD QTLPLNVNPA LPLSPTGLAG SLTNALSNGL LSGGLLGILE NLPLLDILKP GGGTSGGLLG GLLGKVTSVI PGLNNIIDIK VTDPQLLELG LVQSPDGHRL YVTIPLGIKL QVNTPLVGAS LLRLAVKLDI TAEILAVRDK QERIHLVLGD CTHSPGSLQI SLLDGLGPLP IQGLLDSLTG ILNKVLPELV QGNVCPLVNE VLRGLDITLV HDIVNMLIHG LQFVIKV (1-256 aa encoded by BC012549)
靶标信息
PLUNC is the human homolog of murine plunc and is specifically expressed in the upper airways and nasopharyngeal regions. The exact biological function of this protein is not known, however, it has been suggested to be involved in inflammatory responses to irritants in the upper airways. It may also serve as a potential molecular marker for detection of micrometastasis in non-small-cell lung cancer. This gene is the human homolog of murine plunc, and like the mouse gene, is specifically expressed in the upper airways and nasopharyngeal regions. The exact biological function of this gene is not known, however, it has been suggested to be involved in inflammatory responses to irritants in the upper airways. It may also serve as a potential molecular marker for detection of micrometastasis in non-small-cell lung cancer. Multiple transcript variants resulting from alternative splicing in the 3' UTR have been detected, but the full-length nature of only two is known.
仅用于科研。不用于诊断过程。未经明确授权不得转售。
生物信息学
蛋白别名: BPI fold-containing family A member 1; ligand-binding protein RYA3; LPLUNC3; Lung-specific protein X; LUNX; LUNXNASG; Nasopharyngeal carcinoma-related protein; Palate lung and nasal epithelium clone protein; palate, lung and nasal epithelium associated; palate, lung, and nasal epithelium associated; palate, lung, and nasal epithelium clone; palate, lung, and nasal epithelium expressed transcript; protein Plunc; Secretory protein in upper respiratory tracts; short palate; Short PLUNC1; SPLUNC1; SPLUNC1SPURT; SpurtA; tracheal epithelium enriched protein; Tracheal epithelium-enriched protein; unnamed protein product; Von Ebner protein Hl
基因别名: bA49G10.5; BPIFA1; LUNX; NASG; PLUNC; SPLUNC1; SPURT; UNQ787/PRO1606
UniProt ID: (Human) Q9NP55, (Mouse) P97361
Entrez Gene ID: (Human) 51297, (Mouse) 18843